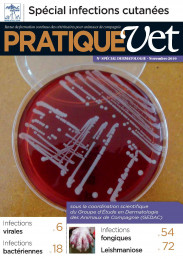

Librairie
Manuel de Psychiatrie du Chien
Nicolas Massal, Vétérinaire comportementaliste, Président de Zoopsy
Muriel Marion, Vétérinaire comportementaliste, Past‑Présidente du GECAF (AFVAC), Vice‑Présidente de Zoopsy
Claude Béata, Vétérinaire spécialiste en médecine du comportement, Vice-Président AFVAC, Président du GECAF (AFVAC), Président d’honneur de ZoopsyComportement
Cet ouvrage a été conçu pour ne pas être exhaustif mais pratique et accessible, toujours à portée de main, ce livre vous ouvre la porte de cette discipline fondamentale qui nous permet d’alléger la souffrance des chiens et de restaurer le bien‑être de tout le groupe.
Année : 2024, Page : 312
Le Chien et son Comportement
Nicolas Massal, Vétérinaire comportementaliste, Président de Zoopsy
Muriel Marion, Vétérinaire comportementaliste, Past‑Présidente du GECAF (AFVAC), Vice‑Présidente de Zoopsy
Claude Béata, Vétérinaire spécialiste en médecine du comportement, Vice-Président AFVAC, Président du GECAF (AFVAC), Président d’honneur de ZoopsyComportement
Après le chat et son comportement (AFVAC Éditions 2016), il est temps d’actualiser nos connaissances sur le chien.
Dans la lignée du travail précédent, nous avons poussé encore plus loin la volonté de travail collaboratif : ce ne sont pas moins de 27 auteurs, 1 généticienne et 26 praticiens, tous diplômés soit du DIE de Vétérinaire comportementaliste soit du DU de Psychiatrie vétérinaire, qui mettent à la disposition de toute l’éq...
Année : 2024, Page : 184
Thérapeutique cardiovasculaire du chien et du chat
Valérie Chetboul, Jonathan Lichtenberger, Anthony Barthélemy, Jean-Louis Pouchelon
Cardiologie
La première édition de cet ouvrage à succès paru en 2004 nécessitait une mise à jour.
Afin de faciliter la prescription, cet ouvrage présente :
- les principales familles en thérapeutique cardiovasculaire avec pour chacune d'elles : les principes d'action, les caractéristiques pharmacocinétiques, pharmacodynamiques et pharmacologiques, les indications, les effets secondaires et indésirables et les interactions médicam...
Année : 2024, Page : 248
Neurologie du chien et du chat, gestes pratiques
Nicolas Granger
Neurologie
Ce livre aborde les particularités de l’examen neurologique dont la sémiologie est décrite à l’aide d’une abondante iconographie. Une démarche « pas à pas » a été privilégiée. Le lecteur y trouvera les gestes de base indispensables à l’élaboration du diagnostic neurologique, à réaliser également dans le cadre des urgences ou de l’examen neuro-ophtalmologique. Le recours aux examens complémentaires d’imagerie est signalé aussi souvent que néces...
Année : 2022, Page : 160
6 numéros spéciaux PratiqueVet à -50 %
Divers
Ostéopathie et Acupuncture, Biothérapie, Cardiologie, Chirurgie, Dermatologie, Endocrinologie, Gastro-Entérologie, Imagerie Médicale, Maladies virales et bactériennes, Management, Médecine Féline, Médecine Interne, Médecine préventive, N.A.C, Neurologie, Nutrition, Alimentation et Diététique, Oncologie, Ophtalmologie, Orthopédie, Physiothérapie / Rééducation, Uro-Néphrologie
Offre 6 numéros spéciaux PratiqueVet pour 95 € (-50 %)*.
* Dans la limite des stocks disponibles.
Année : 2021, Page : 1
Spécial : Zootechnie, médecine préventive et biosécurité chez les Nouveaux Animaux de Compagnie
Bien-être animal, Médecine préventive, N.A.C, Nutrition, Alimentation et Diététique
Année : 2019, Page : 88
Le chat et son comportement
Claude Béata, Gérard Muller, Colette Arpaillange-Vivier, Edith Graff, Dominique Lachapèle, Muriel Marion, Nathalie Marlois, Nicolas Massal, Catherine Mège
Comportement
Ce livre est destiné aux vétérinaires, auxiliaires de santé vétérinaire, éleveurs, « cat lovers » et étudiants pour les aider à relever le défi quotidien que représentent les chats, animaux familiers les plus populaires aujourd’hui. De plus en plus présents dans nos clientèles, leur comportement ne doit plus être un mystère.
Dans nos établissements de soins, il est important que chaque membre de l’équipe, à son niveau puisse intervenir...
Année : 2019, Page : 152
Actualités scientifiques
Ostéopathie et Acupuncture, Biothérapie, Cardiologie, Chirurgie, Dermatologie, Imagerie Médicale, Médecine Interne, N.A.C, Neurologie, Nutrition, Alimentation et Diététique, Ophtalmologie, Orthopédie, Physiothérapie / Rééducation, Urgence et Réanimation
Année : 2018, Page : 88
DERMATOLOGIE
Dermatologie, Parasitologie, Maladies virales et bactériennes
Infections virales
- Manifestations cutanées des maladies virales chez le Chien
- Manifestations cutanées des maladies virales chez le Chat
Infections bactériennes
- Nouvelle classification des staphylocoques
- Staphylocoques résistants à la méticilline en médecine vétérinaire : définition, épidémiologie, conduite à tenir
- Le syndrome de prolifération bactérienne
- ...
Année : 2010, Page : 80
Management
C. Chovet, C. Navarro, P. Buisson, Ph. Melon, L. Hazotte, A. Sénécaut, Y. Content, H. Mateos et JM. Mainguené, Ph. Laravoire, J. Salord, G. Santaner, G. Hannotte, Ph. Goessaert, D. Favre, F. Courouble.
Management
De l’installation à la retraite.Évolutions et révolutions dans la vie d’un vétérinaire et de sa clinique
- S’installer ou changer de local professionnel : intérêt du Géomarketing
- Avantages et inconvénients de la Société d’Exercice Libéral
- Estimation de clientèle : une méthode d’évaluation de clientèle reconnue
- Comment mettre en place un budget prévisionnel
- Apport de la comptabilité analytiqu...
Année : 2008, Page : 68
Génétique et sélection chez le chien
B.Denis
Reproduction-Elevage
Génétique générale
- Caractères qualitatifs et quantitatifs
- Hérédité des caractères qualitatifs
- Hérédité des caractères quantitatifs
- Génétique des populations
Méthodes d'amélioration génétique
- Le choix des reproducteurs
- l'utilisation des reproducteurs
Etude génétique du phénotype du Chien
- Morphologie....
Année : 2007, Page : 320
Ophtalmologie du chien
Collectif GEMO
Ophtalmologie
Des rappels d’anatomie et physiologie sont d’abord présentés. Puis, pourchaque structure, la synthèse des connaissances et techniques d’actualité en diagnostic et thérapeutique est eff ectuée. Des éclairages sur des sujets transversaux –cécité, imagerie, oncologie, urgences– et sur des points essentiels –matériels et techniques chirurgicales, viroses félines– sont proposés.
Année : 2007, Page : 190
Ophtalmologie du chat
Collectif GEMO
Ophtalmologie
Des rappels d’anatomie et physiologie sont d’abord présentés. Puis, pourchaque structure, la synthèse des connaissances et techniques d’actualité en diagnostic et thérapeutique est eff ectuée. Des éclairages sur des sujets transversaux –cécité, imagerie, oncologie, urgences– et sur des points essentiels –matériels et techniques chirurgicales, viroses félines– sont proposés.
Année : 2005, Page : 210
Atlas d'Angiographie Fluorescéinique du fond d'oeil des carnivores domestiques
F. Lescure
Ophtalmologie
Une synthèse des observations en matière d’angiographie fluorescéinique du chien et du chat est rassemblée dans cet ouvrage.
Année : 1998, Page : 1998
Atlas en couleur de Cytologie du Cancer du Chien et du Chat
C. Fournel-Fleury, J.P. Magnol, J.F. Guelfi
Oncologie
Plus de 600 photographies en couleur, légendées dans le détail, illustrent les principaux aspects des cancers dans les meilleures indications des cytoponctions : épanchements cavitaires, adénogramme, myélogramme, tumeurs cutanées et sous-cutanées.
Année : 1994, Page : 432